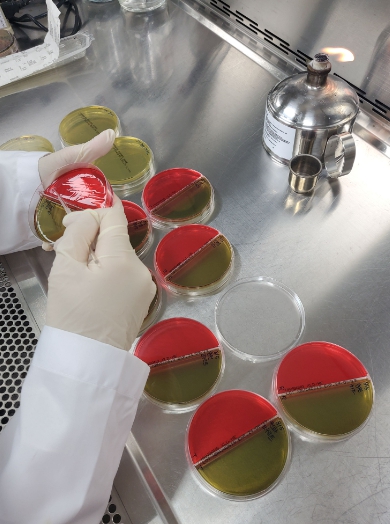

![]() 축산식품 특별수거 검사 |
수거검사 대상은 무작위로 선정된 축산물 제조·판매업소 27개소로, 동물위생시험소가 직접 수거해 검사한다. 검사 항목은 살모넬라, 대장균, 리스테리아 등 주요 식중독균 5종과 보존료·타르색소 등 식품 첨가물이다.
검사 결과 부적합 판정 시 식품의약품안전처 등 관계기관에 알리고 제조·판매업체에 신속하게 통보해 해당 제품 유통을 즉시 차단할 계획이다.
정지영 전남도동물위생시험소장은 “풍요로운 추석을 맞아 도민이 안심하고 드시도록 축산식품 안전성 검사를 집중 실시하겠다”며 “축산물 제조·판매업 관계자께서는 고온다습한 시기이니 축산물 취급·보관 시 위생관리를더욱 철저히 해달라”고 당부했다.
전남지역 축산물 검사를 책임지고 있는 전남도동물위생시험소는 매년 식품의약품안전처가 실시하는 축산물 시험·검사 능력 평가에서 연속 적격기관으로 선정됐다. 축산물 판매·제조업체를 대상으로 연간 1만 8천 건의 축산물 안전성 검사를 하고 있다.
온라인뉴스팀 news@newsjournal.co.kr